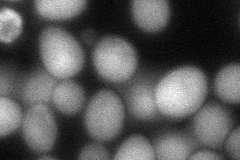

View description
Subunit d of the five-subunit V0 integral membrane domain of vacuolar H+-ATPase (V-ATPase), an electrogenic proton pump found in the endomembrane system; stabilizes VO subunits; required for V1 domain assembly on the vacuolar membrane
Localization:
Intensity:
Fold change:
Significance:
-
C’ GFP library in SD

below threshold16.12 -
N' NOP1pr-GFP in SD

vacuole membrane0 -
N' TEF2pr-mCherry in SD

missing0 -
N' NATIVEpr-GFP in SD

below threshold25.0789 -
N' TEF2pr-VC and Cyto-VN in SD
cytosol73.2538 -
C’ GFP library in SD+DTT

cytosol15.190.94No -
C’ GFP library in SD+H2O2

cytosol18.391.14No -
C’ GFP library in Starvation Media

cytosol17.531.08No -
C’ GFP library on the background of Pup2-DaMP

below threshold -
C’ GFP library on the background of CCT mutant

below threshold14.36660.890784No
